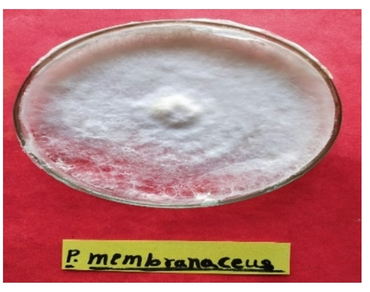
Mushroom cultivation, n                     P. membranaceusn                  , Wheat straw, Maize straw, Biological efficiency

Production of oyster mushroom (P. membranaceus) using various ratios of rice and maize straw with wheat straw
*Article not assigned to an issue yet
Kumawat Archana, Kumawat Gayatri, Wasnikar Alok Raj, Kumawat Hansa, Bishnoi Mayank, Paroda Manish, Bhadouria Mradula
Research Articles | Published: 08 March, 2026
First Page: 0
Last Page: 0
Views: 71
Keywords: Mushroom cultivation, n P. membranaceusn , Wheat straw, Maize straw, Biological efficiency
Abstract
The aggregation of agricultural waste has resulted in several environmental problems, such as air and soil pollution and the spread of insects and pathogens. To address these issues, experiments have evaluate these wastes as substrates for growing Pleurotus mushrooms at College of AJNKVV, Jabalpur, Madhya Pradesh, which are economically feasible and nutritionally beneficial. This experiment aimed to evaluate the use of rice straw and maize straw, with wheat straw in different ration like 100%: 0%, 75%: 25%, 50%: 50%, 25%: 75% and 0: 100% (rice straws: wheat straw and maize straw: wheat straw) to grow P. membranaceus as an edible mushroom. The substrate wheat straw was considered as control. The effects of various substrates on spawn run, pin head initiation, stipe length, stipe width, cap diameter, mushroom yield and biological efficiency (BE). Among all aspects, wheat straw (control) was found as a best substrate with yield (902.10 gm) and BE (90.21%) followed by rice straw 75% + 25% wheat straw (887.51 g and 88.75%) and the lowest was from maize straw 100% (811.75 g and 81.17%) for the production of mushroom.
References
Akram S, Khan R, Iqbal O, Nabeel M, Zaman S, Khanzada N, Khanzada MA, Rajput MA (2024) Enhancing oyster mushroom (Pleurotus spp.) yield performance across various substrates through chemical and biological supplements. Pak J Phytopathol 36(1):141–148
Chang ST, Miles PG (1981) Edible mushroom and their cultivation CRC Press. Boca Raton, Florida 6:555–565
Dawoud MEA, Eweis M (2006) Phytochemical control of edible mushrooms pathogenic bacteria. J Food Agric Environ 4:321
De CCSM, De ALVB, Sales-Campos C, De MMTA, De AMCN (2012) Applicability of the use of waste from different banana cultivars for the cultivation of the oyster mushroom. Braz J Microbiol 43:819–826. https://doi.org/10.1590/S1517-83822012000200048
Dhakal P, Pokhrel A, Bista A, Shah K, Acharya B, Shrestha J (2020) Growth and yield performance of oyster mushroom (Pleurotus ostreatus) on different substrates. Agriways 8(1):1–8
Dinardo MLL, Fracasso JV (2013) Sugarcane straw and the populations of pests and nematodes. Sci Agric 70:305–310. https://doi.org/10.1590/S0103-90162013000500012
Diriba M, Gume B, Abate D (2013) Evaluation of locally available substrates for cultivation of oyster mushroom (Pleurotus ostreatus). Afr J Microbiol Res 7(20):2228–2237
Elattar AM, Hassan S, Awd ASF (2019) Evaluation of oyster mushroom (Pleurotus ostreatus) cultivation using different organic substrates. Alex Sci Exch J 40(July-September):427–440
Ferreira DA, Franco HCJ, Otto R, Vitti AC, Fortes C, Faroni CE, Garside AL, Trivelin PCO (2016) Contribution of N from green harvest residues for sugarcane nutrition in Brazil. GCB Bioenergy 8:859–866. https://doi.org/10.1111/gcbb.12292
Girmay Z, Gorems W, Birhanu G, Zewdie S (2016) Growth and yield performance of Pleurotus ostreatus (Jacq. Fr.) Kumm (oyster mushroom) on different substrates. AMB Express 6:1–7
Han J, Sun R, Huang C, Xie H, Gao X, Yao Q, Gong Z (2024) Effects of different carbon and nitrogen ratios on yield, nutritional value, and amino acid contents of Flammulina velutipes. Life 14(5):598
Iqbal B, Khan H, Saifullah IK, Shah B, Naeem A, Ullah W, Ahmed N (2016) Substrates evaluation for the quality, production and growth of oyster mushroom (Pleurotus florida Cetto). J Entomol Zool Stud 4(3):98–107
Aditya, Jarial RS, Jarial K (2022). Commercial cultivation of the elm oyster mushroom Hypsizygus ulmarius (Agricomycetes) on different substrates and its medicinal benefits. Int J Med Mushrooms, 24(12)
Jin VL, Baker JM, Johnson JMF (2014) Soil greenhouse gas emissions in response to corn stover removal and tillage management across the US cornbelt. Bioenerg Res 7:517–527. https://doi.org/10.1007/s12155-014-9421-0
Maheswari S, Rajarajan P, Pandian PM, Sheeba E, Bayineni VK (2020) Influence of different substrates on growth and yield of Pleurotus ostreatus. J Appl Hortic 22(3):215–219
Mkhize SS, Zharare GE, Basson AK, Mthembu MS, Cloete J (2017) Performance of Pleurotus pulmonarius mushroom grown on maize stalk residues supplemented with various levels of maize four and wheat bran. Food Sci Technol 37:570–577
Muswati C, Simango K, Tapfumaneyi L, Mutetwa M, Ngezimana W (2021) The effects of different substrate combinations on growth and yield of oyster mushroom (Pleurotus ostreatus). Int J Agron 1:9962285
Pegler DN (1977) Pleurotus (agaricals) in india, Nepal Pakishtan kew bulletin pp 501–510.
Sánchez C (2010) Cultivation of Pleurotus ostreatus and other edible mushrooms. Appl Microbiol Biotechnol 85:1321–1337. https://doi.org/10.1007/s00253-009-2343-7
Sharma S, Yadav RKP, Pokhrel CP (2013) Growth and yield of oyster mushroom (Pleurotus ostreatus) on different substrates. J New Biol Reports 2(1):03–08
Sitaula HP, Dhakal R, Geetesh DC, Kalauni D (2018) Effect of various substrates on growth and yield performance of oyster mushroom (Pleurotus ostreatus) in Chitwan, Nepal. Int J Appl Sci Biotechnol 6(3):215–219
Vetayasupom S (2007) Liginocellulosic materials as a possible substrate for Pleurotus ostreatus (Fr.) kummer cultivation. J Agron 6:167–170
Wang D, Sakoda A, Suziki M (2001) Biological efficiency and nutritional value of Pleurotus ostreatus cultivated on spent beer grain. Bioresour Technol 78:293–300
Zárate SJR, Santos MN, Caballero ENM, Martins OG, Herrera AAP (2020) Use of lignocellulosic corn and rice wastes as substrates for oyster mushroom (Pleurotus ostreatus Jacq.) cultivation. SN Appl Sci 2:1–10
Author Information
Department of Plant Pathology, College of Agriculture Jabalpur, Jawaharlal Nehru Krishi Vishwa Vidhalya, Jabalpur, India